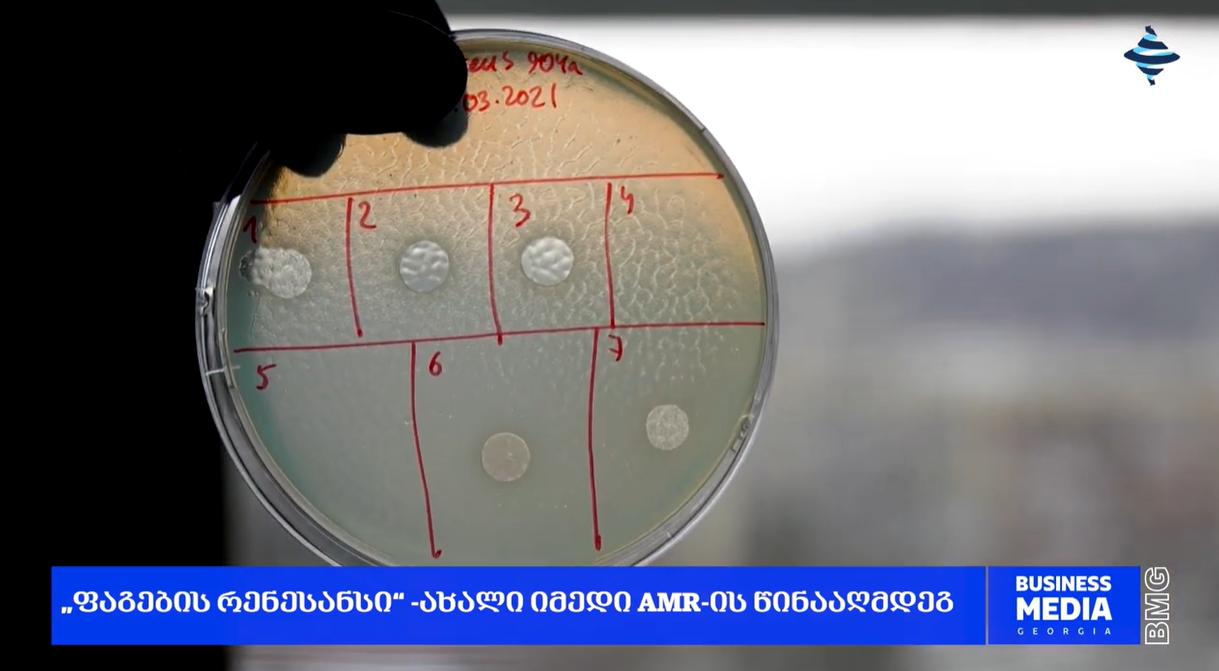

13.07.2025
საქართველო - ფაგოთერაპიის განვითარების პიონერი და ანტიმიკრობული რეზისტენტობის წინააღმდეგ გლობალური პერსპექტივები
ტელევიზია BMG-ის გადაცემაში „ჯანდაცვის სტანდარტი“ - გავიდა სიუჟეტი სათაურით - „ანტიმიკრობული რეზისტენტობა (AMR)“, სადაც გიორგი ელიავას სახელობის ბაქტერიოფაგიის, მიკრობიოლოგიისა და ვირუსოლოგიის ინსტიტუტის დირექტორმა, ბიოლოგიის მეცნიერებათა დოქტორმა, მზია ქუთათელაძემ ისაუბრა - საქართველოში ფაგოთერაპიის გამოყენების და განვითარების ისტორიაზე, ასევე თანამედროვე ეპოქაში, გლობალური საფრთხის - ანტიმიკრობული რეზისტენტობის წინააღმდეგ ელიავას სახელობის ინსტიტუტის შესაძლებლობებისა და პერსპექტივების შესახებ.